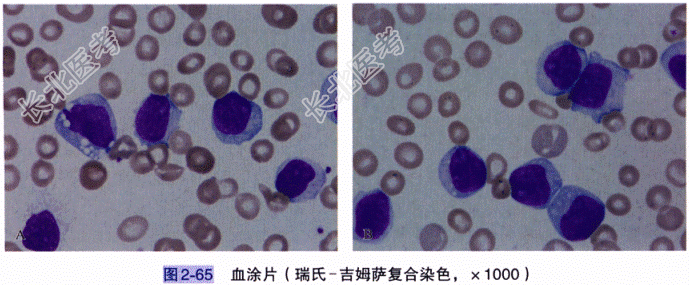

试题详情
- [材料题] 患者,男,74岁。主因“白细胞增高1⁺年,发热伴尿频、尿急、尿痛1⁺周”就诊。门诊查血常规:WBC78.5×10⁹/L,中性粒细胞百分比3.0%,淋巴细胞百分比30.0%,单核细胞百分比0.0%,RBC3.16×10¹²/L,Hb100g/L,PLT91×10⁹/L;外周血涂片显示原幼细胞占67.0%,遂以“急性白血病”收住血液内科。体格检查 T36.5℃,P86次/分,R20次/分,BP129/73mmHg。慢性病容,神志清楚,全身皮肤、黏膜稍苍白,无皮疹及出血点,舌苔白厚;颈部、腋窝及腹股沟触及多处淋巴结肿大,最大直径约3cm,质韧,无压痛,活动欠佳;双肺呼吸音粗,未闻及干、湿啰音及哮鸣音;心率86次/分,律齐,未闻及杂音;全腹软,未见胃肠型及蠕动波,腹部无压痛,无反跳痛及肌紧张,墨菲征阴性;肝肋下约3cm,质韧,无压痛;脾重度肿大,超脐,质韧,伴轻触痛;肝、肾区无叩击痛,肝、肺相对浊音界存在,移动性浊音阴性,肠鸣音3次/分,未闻及气过水声及高调肠鸣音;双下肢水肿。辅助检查:(1)常规检查:①血常规:WBC78.5×10⁹/L,中性粒细胞百分比3.0%,淋巴细胞百分比20.0%,单核细胞百分比0.0%,RBC3.16×10¹²/L,Hb100g/L,PLT91×10⁹/L,外周血涂片提示原幼细胞占77.0%,超敏C反应蛋白7.89mg/L。②外周血淋巴细胞亚群检测:总T淋巴细胞百分比18.76%,辅助/诱导T淋巴细胞百分比12.32%,抑制/细胞毒T淋巴细胞百分比5.94%,B淋巴细胞百分比78.22%,NK细胞百分比1.34%。③其他检查:腹部、泌尿系统B超提示肝、脾大,腹膜后淋巴结肿大,胆囊增大,胆汁淤滞。胸部CT显示两侧腋窝及纵隔淋巴结增多肿大,脾大。(2)细胞形态学检查:①血象结果:外周血白细胞显著增高,血涂片原幼细胞占77.0%,建议做骨髓细胞形态学检查(图2-65)。②骨髓象结果:骨髓增生极度活跃,粒:红=1:1,粒系、红系极度受抑制,淋巴细胞恶性增生,幼淋巴细胞占95.5%;MPO阴性,PAS呈不同程度阳性,ACP阳性。考虑淋巴系统增殖性肿瘤(幼淋巴细胞白血病可能性大),请结合流式细胞学、细胞遗传学和基因检测结果综合分析(图2-66)。(3)流式细胞学分析:送检标本中可见87.4%的成熟B淋巴细胞,其免疫表型为CD19(+)、CD20(+)、CD22(+)、CD23(+)、CD79a(+)、FMC7(+)、ZAP70(+)、CD38(+),CD5(-)、CD10(-),胞膜免疫球蛋白sIgM表达明显;支持B-PLL。(4)临床诊断:支持幼淋巴细胞白血病(PLL)。

- 简答题1、该案例诊断的依据是什么?
关注下方微信公众号,搜题查看答案

- 简答题2、实验检查结果解读及报告审核要点是什么?
关注下方微信公众号,搜题查看答案

- 简答题3、与哪些疾病相鉴别?
关注下方微信公众号,搜题查看答案

热门试题
- 1、该案例诊断的依据是什么?2、实验检查
- 1、糖化血红蛋白检测中最易受HbF干扰的
- 1、患者最可能诊断为什么?2、遗传性血小
- 1、本病最可能的诊断是什么?2、为了本病
- 1、可能的诊断包括哪些?2、该患者行进一
- 1、该患者应考虑的诊断有哪些?2、为进行
- 1、血细胞免疫分型在该病例诊断中的作用是
- 1、该案例的诊断依据是什么?2、形态学、
- 1、该患者最有可能的诊断为什么?2、外周
- 1、最可能的诊断是什么?2、如需进一步确
- 1、该患者可能的诊断是什么?2、为明确诊
- 1、该患者最可能的诊断是什么?2、患者确
- 1、本病最可能的诊断是什么?2、确诊本病
- 1、为明确诊断,需要进行的筛检试验有哪些
- 1、该患者的骨髓细胞学检查有何临床意义?
- 1、最可能的诊断是什么?2、还需要做什么
- 1、本病最有可能诊断是什么疾病?2、在询
- 1、患者可诊断为什么?2、本例溶血性贫血
- 1、该患者最可能的诊断是什么?2、为进一
- 1、采集病史时应特别注意询问什么?2、患